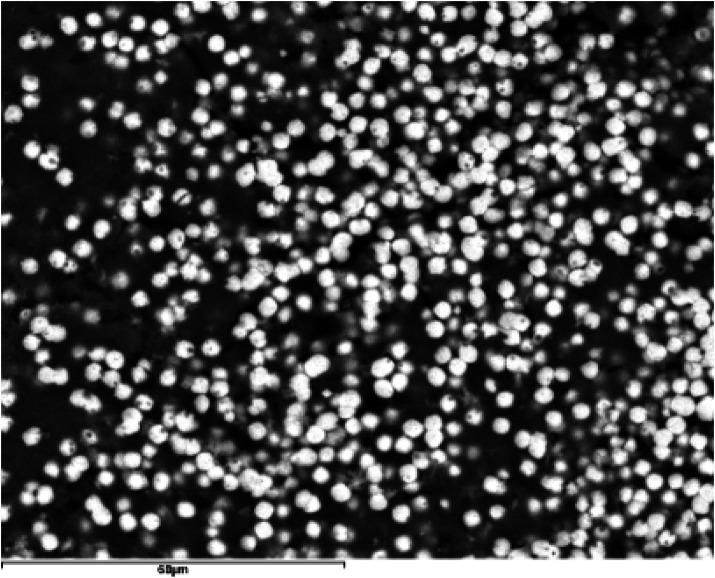

涎腺结石病的进化构象模型
Evolutionary conformation model of salivary gland lithiasis.
作者信息
Sánchez Barrueco Álvaro, López-Acevedo Cornejo María Victoria, Aragonés Sanzen-Baker William, López-Andrés Sol, Díaz Tapia Gonzalo, Alcalá Rueda Ignacio, Santillán Coello Jessica Mireya, Cenjor Español Carlos, Villacampa Aubá José Miguel
机构信息
Medicine Faculty, Alfonso X el Sabio University, Madrid, Spain.
ENT and Cervicofacial Surgery Department, Fundación Jiménez Díaz University Hospital, Madrid, Spain.
出版信息
Front Oral Health. 2025 Jun 5;6:1610977. doi: 10.3389/froh.2025.1610977. eCollection 2025.
INTRODUCTION
Salivary stones, or sialoliths, are calcified concretions forming within salivary glands and their ducts through a two-stage process: an initial formation of a central core via precipitation of inorganic material mediated by organic substances, followed by layering of additional organic and inorganic material. Substrates for sialolith formation include mucoid agglomerates, organic vesicles, foreign bodies, and bacterial biofilms. Understanding the detailed structure of sialoliths may aid in developing specific preventive or therapeutic strategies.
MATERIALS AND METHODS
This study analyzed 137 sialoliths from 102 patients treated across three university hospitals. Stones were extracted via sialendoscopy, direct extraction, or spontaneous extrusion. Structural and compositional analyses were conducted using scanning electron microscopy (SEM-EDX) and x-ray diffraction (XRD).
RESULTS
Most sialoliths were from the submandibular gland (82%), with the remainder from the parotid gland (18%). Parotid stones predominantly exhibited irregular shapes, while submandibular stones were generally ellipsoidal. All stones demonstrated an oolitic structure characterized by a central core surrounded by concentric layers and frequently associated with bacteria. Mineral composition predominantly included octacalcium phosphate (OCP), hydroxyapatite, and whitlockite. Larger sialoliths exhibited a higher proportion of hydroxyapatite, indicating increased crystallinity compared to OCP.
DISCUSSION
Despite diverse origins and locations, sialoliths share common morphological and compositional traits. Their formation begins with heterogeneous nucleation of calcium phosphates around organic spherules, likely induced by bacterial biofilms. These initial nuclei aggregate into a central core upon which additional layers of organic and inorganic materials deposit progressively. This layering increases the size and crystallinity of the sialoliths over time. The coexistence of amorphous phases and structural heterogeneity within layers explains the variability among stones. Detailed SEM-EDX analysis supports a unified conformational model for sialoliths that integrates the interplay of organic substrates, inorganic minerals, bacterial biofilms, and temporal factors.
CONCLUSIONS
Sialoliths are oolitic aggregates featuring a central core surrounded by concentric layers composed of organic and inorganic materials. Their formation process involves initial heterogeneous nucleation, bacterial influence, and progressive crystallization. This universal conformational model effectively describes sialolith formation irrespective of patient-specific or anatomical variations.
引言
涎石,即唾液腺结石,是在唾液腺及其导管内通过两个阶段形成的钙化凝块:首先通过有机物质介导的无机物质沉淀形成一个中心核,随后是额外的有机和无机物质分层堆积。涎石形成的底物包括黏液样聚集体、有机小泡、异物和细菌生物膜。了解涎石的详细结构可能有助于制定特定的预防或治疗策略。
材料与方法
本研究分析了来自三家大学医院接受治疗的102例患者的137颗涎石。通过唾液腺内镜检查、直接摘除或自然排出取出结石。使用扫描电子显微镜(SEM-EDX)和X射线衍射(XRD)进行结构和成分分析。
结果
大多数涎石来自下颌下腺(82%),其余来自腮腺(18%)。腮腺结石主要呈不规则形状,而下颌下结石通常为椭圆形。所有结石均表现出鲕状结构,其特征是有一个被同心层包围的中心核,且常与细菌相关。矿物质成分主要包括磷酸八钙(OCP)、羟基磷灰石和白磷钙矿。较大的涎石中羟基磷灰石的比例更高,表明与OCP相比结晶度增加。
讨论
尽管涎石的起源和位置各不相同,但它们具有共同的形态和成分特征。它们的形成始于围绕有机小球的磷酸钙异质成核,可能由细菌生物膜诱导。这些初始核聚集成一个中心核,在其上有机和无机材料的额外层逐渐沉积。随着时间的推移,这种分层增加了涎石的大小和结晶度。层内非晶相和结构异质性的共存解释了结石之间的变异性。详细的SEM-EDX分析支持了一个统一的涎石构象模型,该模型整合了有机底物、无机矿物质、细菌生物膜和时间因素之间的相互作用。
结论
涎石是鲕状聚集体,具有由有机和无机材料组成的同心层包围的中心核。它们的形成过程涉及初始异质成核、细菌影响和渐进结晶。这个通用的构象模型有效地描述了涎石的形成,而不考虑患者特异性或解剖学变异。